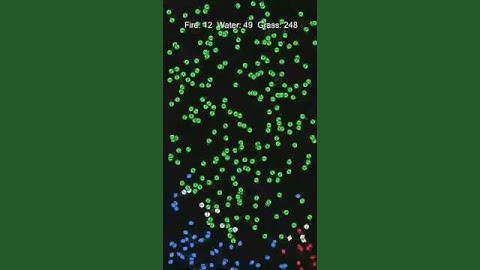
🔥 vs 💧 vs 🌿 : Which team will survive? #unity  #simulation #WA #rockpaperscissors

⬇ DOWNLOAD NOW
Jika muncul iklan pop-up, tutup lalu klik tombol kembali
Download lagu I Made a Rock-Paper-Scissors Simulation in Unity 3D! #madewithunity #unity3dengine #haydenjohnson secara gratis hanya untuk keperluan promosi. Dukung artis favorit kamu dengan membeli musik original di iTunes atau platform resmi lainnya.
 Rock Paper Scissors Made with Unity
Rock Paper Scissors Made with Unity Rock Paper Scissors Battle! - My first Unity game
Rock Paper Scissors Battle! - My first Unity game 🔥 vs 💧 vs 🌿 : Which team will survive? #unity #simulation #WA #rockpaperscissors
🔥 vs 💧 vs 🌿 : Which team will survive? #unity #simulation #WA #rockpaperscissors Rock Paper Scissors | Game Effects #MadeWithUnity
Rock Paper Scissors | Game Effects #MadeWithUnity Fire vs Water vs Grass: Three-Way Standoff #rockpaperscissors #unity #simulation
Fire vs Water vs Grass: Three-Way Standoff #rockpaperscissors #unity #simulation Rock-Paper-Scissors (100-a-side)
Rock-Paper-Scissors (100-a-side) SECV4143: Rock Paper Scissors 2D Game Tutorial Unity
SECV4143: Rock Paper Scissors 2D Game Tutorial Unity Rock Paper Scissors Minus One in Unity | Squid Game | Devlog
Rock Paper Scissors Minus One in Unity | Squid Game | Devlog